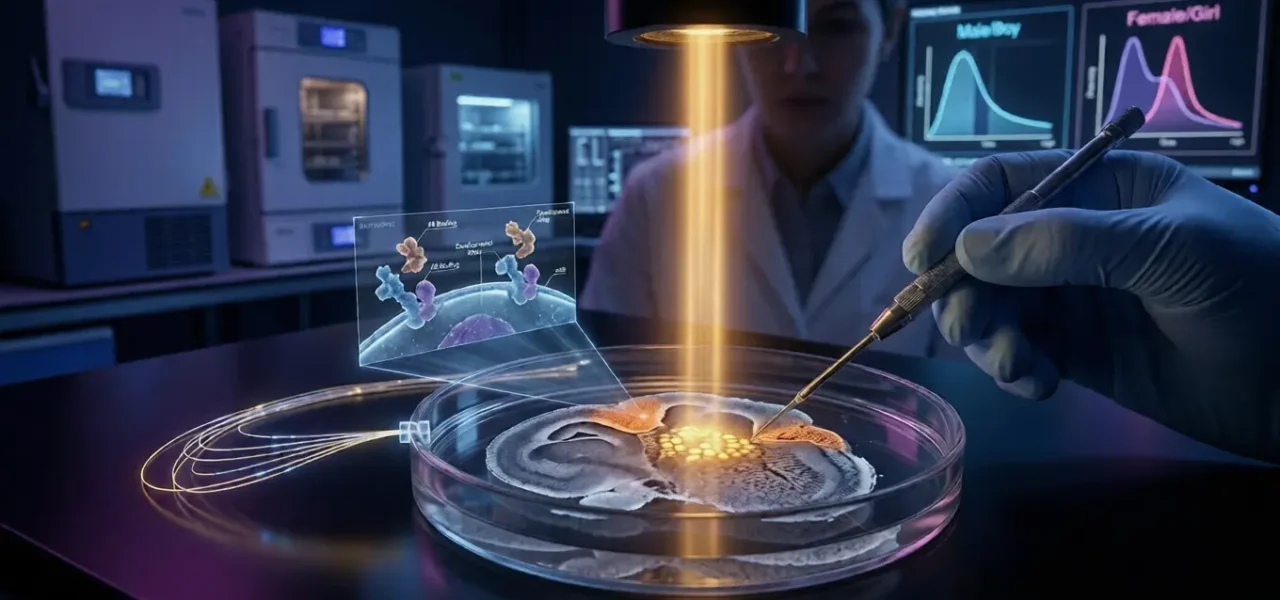
New research shows a common male hormone keeps cancer cells in a permanent “growth state,” making them impossible to kill

New research shows a common male hormone keeps cancer cells in a permanent “growth state,” making them impossible to kill
For years, pediatric oncologists have been haunted by a cruel statistical anomaly: Posterior Fossa Type A (PFA) ependymoma, a devastating brain tumor that strikes infants, is significantly more common—and far more lethal—in boys than in girls. Until now, the reason for this gender gap was a medical mystery.
A groundbreaking study published in the journal Nature has finally cracked the code. An international team of researchers has discovered that the culprit isn’t a genetic mutation or a chromosomal fluke, but rather androgens—the hormones typically associated with male development.
The Science of Stalled Development
Unlike many adult cancers, PFA ependymoma doesn’t have a clear “broken” gene. Instead, it is a cancer of “stalled development.” Normally, embryonic brain cells in the hindbrain follow a strict timeline, maturing from stem-like cells into functional neurons and glia.
The researchers found that in males, androgen activity actually slows down this maturation process. While female brain cells “hurry up” and mature, male cells linger in a primitive, highly proliferative state. If a tumor begins to form during this window, the presence of androgens acts like gasoline on a fire, keeping the cancer cells in a “growth-prone” state where they can multiply indefinitely.
The Shock Factor: Hormones vs. Chromosomes
To prove it was the hormones and not the XY chromosomes, scientists used a “four-core genotype” model. The results were undeniable: regardless of whether the cells were XX or XY, the introduction of androgens (like testosterone) immediately boosted tumor growth and increased “stemness”—the ability of cancer cells to resist treatment and regenerate.
The most shocking find? Female sex hormones, like estradiol, had no effect on the tumor. The cancer is specifically tuned to “listen” to male hormonal signals, explaining why boys face a 40% higher diagnosis rate and a much bleaker prognosis.
The “Life-Change” Angle: A New Hope for Treatment
This discovery isn’t just a win for academic science; it is a massive breakthrough for families facing an “untreatable” diagnosis. Currently, the only weapons against PFA ependymoma are high-risk surgery and radiation, which are often insufficient.
How this changes the future:
-
Anti-Androgen Therapy: Since the tumor relies on androgen signals to stay “immature” and aggressive, scientists believe that existing androgen-blocking drugs—often used for adult prostate cancer—could be repurposed to “starve” these pediatric tumors.
-
Forcing Differentiation: By blocking the hormone, doctors could potentially force the cancer cells to “grow up” and mature into normal, non-cancerous brain tissue, effectively neutralizing the threat without the need for toxic chemotherapy.
-
Early Screening: Understanding this hormonal link may allow for earlier detection in high-risk male infants, catching the “stalled development” before it turns into a lethal mass.
While more clinical trials are needed, the “Nature” study has provided the first mechanistically grounded target for a disease that has outsmarted doctors for decades. We are no longer just fighting a tumor; we are learning how to turn off its engine.


